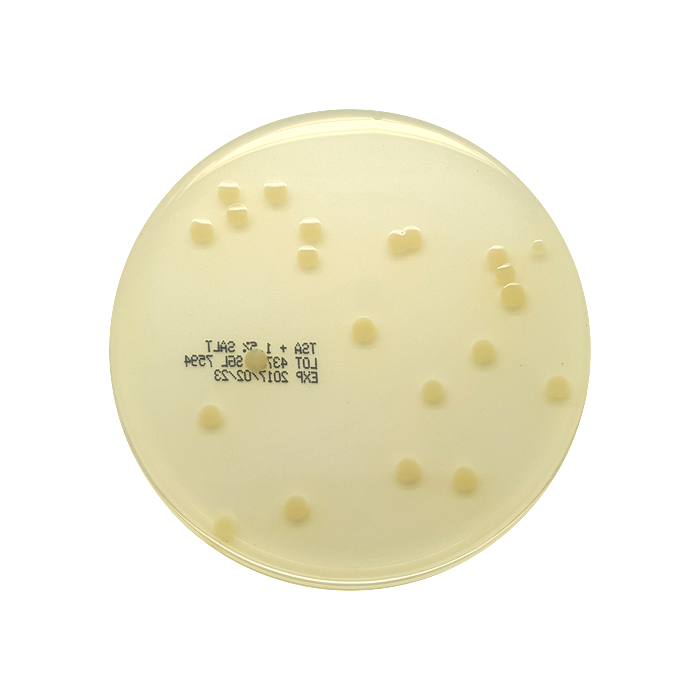

Tryptic soy agar msds
Tryptic Soy Agar Msds. Caso agar casein soybean digest agar tryptone soya agar tsa find msds or sds a coa data sheets and more information. 200 ml in 250 ml bottle with blue screw cap and 3 loci 6 bottles per box synonym. Company identification and product information product name or identity. Find millipore 22091 msds related peer reviewed papers technical documents similar products more at sigma aldrich.

Tryptic soy agar product number. Find millipore 22091 msds related peer reviewed papers technical documents similar products more at sigma aldrich. Product and company identification product name. Microbiological examination of non sterile products culture of a wide variety of microorganisms packaging. Light beige homogeneous powder prepared appearance. Tryptic soy agar manufacturer s name.
Company identification and product information product name or identity.
Identification 1 1 product identifier name tryptic soy agar plates product number t0144 1 2 relevant identified uses of the substance or mixture and uses advised against relevant identified uses general use 1 3 details of the supplier of the safety data sheet teknova 2290 bert dr. Plain light amber agar. Tryptic soy agar for microbiology nutriselect plus. Material safety data sheet or sds for tryptic soy agar 105458 from merck for download or viewing in the browser. Find millipore 22091 msds related peer reviewed papers technical documents similar products more at sigma aldrich. Microbiological examination of non sterile products culture of a wide variety of microorganisms packaging.

Tryptic soy agar plates. Ep usp jp iso and fda bam granucult find msds or sds a coa data sheets and more information. Company identification and product information product name or identity. Material safety data sheet version 5 0 revision date 09 05 2012 print date 02 10 2014 1. Material safety data sheet section 1.
 Source: tokopedia.com
Source: tokopedia.com
200 ml in 250 ml bottle with blue screw cap and 3 loci 6 bottles per box synonym. 200 ml in 250 ml bottle with blue screw cap and 3 loci 6 bottles per box synonym. Read more tryptic soy agar used for the isolation and cultivation of nonfastidious and fastidious microorganisms can be prepared with or without blood or enrichments working concentration. Tryptic soy agar manufacturer s name. Tryptic soy agar product number.

Microbiological examination of non sterile products culture of a wide variety of microorganisms packaging. 517 372 9200 740 east shiawassee fax no. Ep usp jp iso and fda bam granucult find msds or sds a coa data sheets and more information. Caso agar soybean casein digest agar tsa tryptone soya agar. Company identification and product information product name or identity.

Plain light amber agar. 40 g l dehydrated appearance. Product and company identification product name. Microbiological examination of non sterile products culture of a wide variety of microorganisms packaging. 517 372 0108 lansing michigan 48912 e mail.
 Source: mkldiagnostics.com
Source: mkldiagnostics.com
Sigma aldrich 3050 spruce street saint louis mo 63103 usa telephone. Tryptic soy agar manufacturer s name. Material safety data sheet section 1. Tryptic soy agar acc. Caso agar casein soybean digest agar tryptone soya agar tsa find msds or sds a coa data sheets and more information.
 Source: merckmillipore.com
Source: merckmillipore.com
Light beige homogeneous powder prepared appearance. Light beige homogeneous powder prepared appearance. Tryptic soy agar plates. Identification 1 1 product identifier name tryptic soy agar plates product number t0144 1 2 relevant identified uses of the substance or mixture and uses advised against relevant identified uses general use 1 3 details of the supplier of the safety data sheet teknova 2290 bert dr. Sigma aldrich 3050 spruce street saint louis mo 63103 usa telephone.

Tryptic soy agar ep usp application. Microbiological examination of non sterile products culture of a wide variety of microorganisms packaging. 517 372 0108 lansing michigan 48912 e mail. Light beige homogeneous powder prepared appearance. Find millipore 22091 msds related peer reviewed papers technical documents similar products more at sigma aldrich.

Identification 1 1 product identifier name tryptic soy agar plates product number t0144 1 2 relevant identified uses of the substance or mixture and uses advised against relevant identified uses general use 1 3 details of the supplier of the safety data sheet teknova 2290 bert dr. Tryptic soy agar for microbiology nutriselect plus. Tryptic soy agar sds safety data sheet for tryptic soy agar 105458. Sigma aldrich 3050 spruce street saint louis mo 63103 usa telephone. View product specific information msds references and buying faq.

Caso agar casein soybean digest agar tryptone soya agar tsa find msds or sds a coa data sheets and more information. 517 372 0108 lansing michigan 48912 e mail. Caso agar soybean casein digest agar tsa tryptone soya agar. Tryptic soy agar plates. Find millipore 22091 msds related peer reviewed papers technical documents similar products more at sigma aldrich.

517 372 0108 lansing michigan 48912 e mail. Tryptic soy agar manufacturer s name. Material safety data sheet or sds for tryptic soy agar 105458 from merck for download or viewing in the browser. Company identification and product information product name or identity. Ep usp jp iso and fda bam granucult find msds or sds a coa data sheets and more information.
 Source: alibaba.com
Source: alibaba.com
Material safety data sheet kisan bio co ltd. Product and company identification product name. Tryptic soy agar for microbiology nutriselect plus. Company identification and product information product name or identity. Plain light amber agar.
Source: sglab.com
Source: sglab.com
Material safety data sheet or sds for tryptic soy agar 105458 from merck for download or viewing in the browser. Tryptic soy agar acc. Identification 1 1 product identifier name tryptic soy agar plates product number t0144 1 2 relevant identified uses of the substance or mixture and uses advised against relevant identified uses general use 1 3 details of the supplier of the safety data sheet teknova 2290 bert dr. Find millipore 22091 msds related peer reviewed papers technical documents similar products more at sigma aldrich. 1 800 325 5832 fax.
 Source: alibaba.com
Source: alibaba.com
Company identification and product information product name or identity. 517 372 0108 lansing michigan 48912 e mail. Tryptic soy agar plates. Microbiological examination of non sterile products culture of a wide variety of microorganisms packaging. Company identification and product information product name or identity.
 Source: yumpu.com
Source: yumpu.com
Plain light amber agar. 2f kisan b d 86 2 yangjae dong seocho gu seoul 137 890 south korea tel. Tryptic soy agar sds safety data sheet for tryptic soy agar 105458. Ep usp jp iso and fda bam granucult find msds or sds a coa data sheets and more information. Sigma aldrich 3050 spruce street saint louis mo 63103 usa telephone.
 Source: emdmillipore.com
Source: emdmillipore.com
Read more tryptic soy agar used for the isolation and cultivation of nonfastidious and fastidious microorganisms can be prepared with or without blood or enrichments working concentration. 1 800 325 5832 fax. 2f kisan b d 86 2 yangjae dong seocho gu seoul 137 890 south korea tel. 200 ml in 250 ml bottle with blue screw cap and 3 loci 6 bottles per box synonym. Tryptic soy agar sds safety data sheet for tryptic soy agar 105458.
If you find this site convienient, please support us by sharing this posts to your favorite social media accounts like Facebook, Instagram and so on or you can also save this blog page with the title tryptic soy agar msds by using Ctrl + D for devices a laptop with a Windows operating system or Command + D for laptops with an Apple operating system. If you use a smartphone, you can also use the drawer menu of the browser you are using. Whether it’s a Windows, Mac, iOS or Android operating system, you will still be able to bookmark this website.






